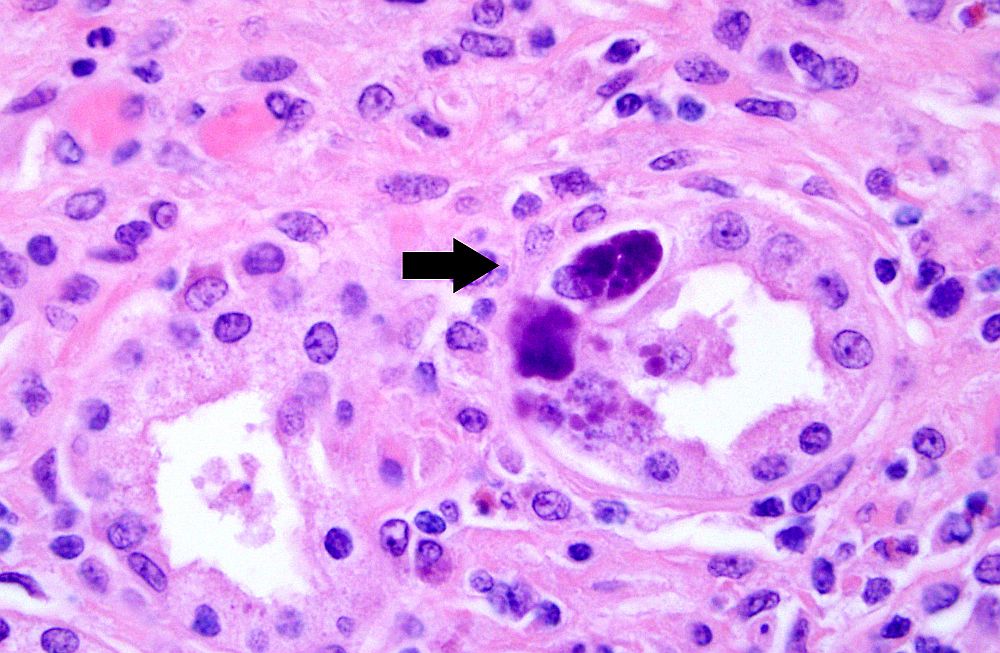

Adenowiroza - tajemnicza choroba wirusowa młodych gołębi budząca postrach wśród hodowców
← PowrótAdenowiroza - tajemnicza choroba wirusowa młodych gołębi budząca postrach wśród hodowców
Adenowiroza - choroba młodych gołębi
Adenowiroza, to ostatnio bardzo duży problem w hodowlach gołębi pocztowych i ozdobnych. Choroba ta budzi postrach wśród hodowców i coraz częściej jest przyczyną dużych strat młodych gołębi. Adenowirusy, to małe dwudziestościenne bezotoczkowe wirusy wielkości 74-90nm. Zawierają dwuniciowy DNA oraz 252 podjednostki strukturalne zwane kapsomerami. Namnażają się one w jądrach zakażonych komórek tworząc charakterystyczne ciałka wtrętowe, które można zobaczyć w badaniu histologicznym, mikroskopowym lub immunofluorescencyjnym. (Kosters 2002).
To zakażenie dzieli się na dwa typy: Adenowiroza typ I i Adenowiroza typ II. Adenowiroza typ I to poważny problem u ptaków młodych. Najczęściej występującymi są przypadki u ptaków starszych niż 6-cio miesięczne, starsze gołębie nabywają odporności wiekowej.
W większości przypadków najbardziej typowym objawem klinicznym jest wodnista biegunka u wszystkich młodych gołębi w stadzie, niekiedy obserwuje się też zwracanie z wola (fot.1).
Chore ptaki szybko tracą wagę. Jeśli nie dojdzie do powikłań bakteryjnych, wracają do zdrowia po 7 dniach. (Raue 2008) Choroba pojawia się zazwyczaj w trakcie lotów młodych gołębi pocztowych, a więc miesiące sierpień - wrzesień, choć może występować w okresie od kwietnia do września, młode gołębie zakażają się od zainfekowanych osobników w trakcie transportu na loty. Wirus atakuje nabłonek jelit, co doprowadza do znacznego uszkodzenia funkcjonowania przewodu pokarmowego. Uszkodzone są także mechanizmy obronne jelit, co często prowadzi do namnażania się bakterii obecnych w przewodzie pokarmowym, zwłaszcza E. coli. Intensywne namnożenie tej bakterii prowadzi do takich objawów jak biegunka koloru zielonkawego, niekiedy pienista, postępujące wychudzenie, silne osłabienie, co w końcu powoduje zejście śmiertelne (Becker 2010). Duże ilości wirusa wydalane są z kałem, tak że w ciągu 4-5 dni dochodzi do zakażenia innych młodych gołębi w stadzie. Nie należy lotować chorych gołębi oraz tych, u których można podejrzewać zakażenie.
W przypadku zakażenia adenowirusem typu II objawy są bardzo słabo widoczne, niekiedy jedynie żółtawy, płynny kał i zwracanie z wola. To nowa niedawno odkryta postać tej groźnej choroby. Chorobę po raz pierwszy opisał Herdt i WSP w 1995 roku. Pierwszy raz została stwierdzona w październiku 1992 roku w stadzie belgijskich gołębi pocztowych. Główne objawy jakie wtedy zaobserwowano to były nagłe upadki we wszystkich grupach wiekowych gołębi. Kliniczne objawy są słabo wyrażone. Najczęściej obserwujemy tylko żółtawy i płynny kał oraz zwracanie z wola. Gołębie są senne, mają nadmierne pragnienie i brak apetytu. Ptaki najczęściej padają w ciągu 24 godzin a bardzo rzadko przeżywają 48 godzin. Podawanie jakichkolwiek antybiotyków nie ma żadnego wpływu na przebieg infekcji. Późniejsze badania wykazały śmiertelność średnio ok. 30% przy tej chorobie (Sudhoff 2014).
W ambulatorium Instytutu Chorób Ptaków Uniwersytetu w Gent (Belgia) w 2010 roku stwierdzono adenowirusowe zapalenie wątroby typu II w 120 przypadkach na 1600 gołębi badanych w ciągu tego roku. 60% gołębi sekcjonowanych z objawami tego schorzenia to są samice. Z dotychczasowych badań prowadzonych w Niemczech i Belgi wynika, że choroba występuje u gołębi w wieku od 10 dni do 6 lat (Fritzsche 1998).
Stwierdzono, że w 60% stad choroba rozpoczęła się od jednej grupy wiekowej oraz, że w 7% przypadków objęła wszystkie grupy wiekowe. Bardzo często obserwujemy, że pozostałe gołębie w innych grupach wiekowych nie wykazują żadnych objawów klinicznych. Hodowcy często obserwowali także, że jeśli młode po padłych rodzicach samodzielnie pobierały pokarm lub były karmione przez inne gołębie to rozwijały się normalnie. Rozprzestrzenienie wirusa nie zostało dotychczas dokładnie zbadane, jednak przypadki choroby występują częściej u gołębi pocztowych niż ozdobnych.
Nie zaobserwowano tutaj roli czynników stresotwórczych np. pierzenie, wystawy, na częstotliwość występowania tej choroby.
Podczas badania sekcyjnego padłych gołębi na adenowirozę I i II widzimy najczęściej bardzo powiększoną żółtawo zabarwioną wątrobę (fot. 2).
Przy adenowirozie typu II bardzo typowy jest brak powiększenia śledziony, który jest charakterystyczny przy adenowirozie typu I (Dorrestein 2007).
Przy adenowirozie typu I śledziona jest silnie obrzęknięta o okrągłych krawędziach koloru ciemno-wiśniowego z fioletowymi licznymi wynaczynieniami. W przypadku adenowirozy typu I obserwujemy silny przerost błony śluzowej jelita cienkiego z licznymi wybroczynami. Brak zmian zapalnych w jelitach występuje przy adenowirozie typu II. Chorobę różnicujemy ze Spironukleozą, Herpeswirozą, Salmonellozą, Pasterelozą oraz Kapilariozą. Rozpoznaniem tej choroby jest badanie histopatologiczne wątroby. W preparatach widzimy wtedy charakterystyczne ciałka wtrętowe (fot.3).
Dostępne też są standardowe badania molekularne wirusologiczne typu PCR. Duże ilości wirusa wydalane są z kałem, dlatego bardzo dobrym materiałem do badań molekularnych są wymazy z kloaki od podejrzanych gołębi.(Becker 2008)
Adenowiroza jest chorobą wirusową dlatego nie działają na nią antybiotyki. Przy leczeniu tej choroby używamy kombinacji różnych immunomodulatorów odporności oraz od niedawna udowodniono skuteczność w zwalczaniu tego rodzaju wirusa produktem SILVECO+ Gołąb. Ważną rzeczą w terapii jest zwalczanie bakteryjnych infekcji towarzyszących zakażeniu np. E. coli, Shigella, Enterococcus, itd. Ostatnio bardzo często obserwuje się też razem z tą chorobą silne infekcje grzybicze wola. Może być to spowodowane silną ekspozycją na mykotoksyny w karmie, które uszkadzając układ odpornościowy, sprzyjają pojawieniu się adenowirozy. (Krautwald 2008) Dlatego ważna jest profilaktyka. Jedyną metodą na ograniczenie ryzyka wystąpienia zakażenia adenowirusem jest przestrzeganie zasad higieny. Szczególną uwagę należy zwrócić na to, aby: nie włączać do stada gołębi niewiadomego pochodzenia, przed włączeniem gołębia do stada poddać go przynajmniej czterotygodniowej kwarantannie, unikać wszystkich czynników upośledzających sprawność układu odpornościowego gołębi (zatrucia, stres), regularnie szczepić gołębie przeciw chorobom zakaźnym (paramyksowiroza, ospa, salmonella i od niedawna dostępną szczepionką trójskładnikową PHA), regularnie zwalczać inwazje kokcydii i robaczyc jelitowych. Dodatkowo podczas lotów młodych warto systematycznie podawać ziołowe immunomodulatory odporności jak np. ADENO-VET w żelu, ANTYWIR-VET czy IMMUNO-VET. Preparaty te wzmacniają układ odpornościowy gołębia dzięki czemu obniżają prawdopodobieństwo wystąpienia tej infekcji wirusowej. (Kosters 2010).
Poza tym dobrze usuwać zalegający płyn w wolu i systematycznie przepłukiwać wole rozcieńczonym roztworem preparatu ziołowego z oregano np. OREGO-VET. Po zaobserwowaniu objawów należy też szybko zmienić karmę na lekko-strawną np. czyste ziarna z ziołami wspomagającymi układ trawienny np. DIARO-VET (regeneruje kosmki jelitowe i stabilizuje funkcjonowanie układu pokarmowego). Do tego wskazane jest też okresowe zastosowanie preparatów neutralizujących mykotoksyny w karmie np. MYCO-VET. W żadnym wypadku podczas adenowirozy nie powinno się podawać karm zawierających duże ilości kukurydzy, grochu i nasion oleistych. Kukurydza i nasiona oleiste są ciężko strawne i mogą pogłębiać chorobę lub wydłużyć proces chorobowy.
W ciężkich przypadkach adenowirozy w swojej praktyce stosuje kombinację skomplikowanych leków przeciwwirusowych ze specjalistycznymi immunomodulatorami odpornościowymi stymulującymi odporność przeciwwirusową. Podawanie kombinacji 4-5 antybiotyków w „cudownych zachodnich preparatach bez składu” najczęściej kończy się masowymi upadkami gołębi i silnym wzrostem lekooporności w gołębniku. Związane jest to, z tym że zniszczenie wirusa antybiotykiem jest fizycznie niemożliwe. Wszystkie antybiotyki działają tylko przeciwbakteryjnie. Większość antybiotyków powoduje też chwilowy spadek odporności, co sprzyja szybszemu niepohamowanemu namnażaniu się cząstek wirusa w organizmach gołębi.
Bardzo ważną rolę odgrywają okresowe, kontrolne badania lekarskie przy zabezpieczaniu gołębi przed adenowirozą, gdyż choroba ta atakuje głównie gołębie ze słabszą odpornością. Adenowiroza jest przez hodowców gołębi bardzo często mylona z innymi chorobami gołębi, przy których występują wymioty np. kandydoza, zatrucia, rzęsistek, kwasica wola.
W mojej praktyce weterynaryjnej układane są różne programy zabezpieczające przed adenowirozą na bazie różnych grup immunomodulatorów odporności i indywidualnych programów szczepienia gołębi. Jeśli hodowcy zechcą mogę ułożyć i wdrożyć w ich hodowlach programy zapobiegania chorobie młodych.
lek. wet. Mariusz Krawczyński - specjalista chorób drobiu oraz ptaków ozdobnych.
Specjalistyczny Gabinet „Pod Skrzydłami”
ul. Lazurowa 1, 96-500 Sochaczew
tel. 691-514-030
e-mail: mariusz.krawczynski@gabinetpodskrzydlami.pl
Fotografie autorstwa Mariusza Krawczyńskiego:
fot. 1 - Biegunka u gołębi w przebiegu adenowirozy.
fot. 2 - Wątroba z charakterystycznymi zmianami martwiczymi w przebiegu adenowirozy.
fot. 3 - Ciałka wtrętowe adenowirusa w komórkach wątroby gołębia.
fot. 4 - Wątroba ze zmianami adenowiroza typ II.
Galeria zdjęć